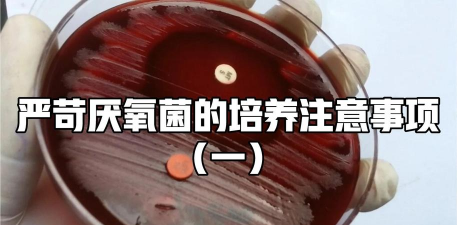
家庭养花用生根粉

搞笑养花短剧推荐
当然可以!以下是一些适合搞笑养花短剧的推荐,适合用来轻松娱乐或作为养花小助手的趣味内容:
1. 《花花大作战》
- 剧情简介:主角是一位花友,每天忙碌于浇水、施肥、修剪,却总因疏忽导致植物生病。他试图用各种搞笑方法“拯救”花朵,结果总是适得其反,最终在朋友们的帮助下终于学会正确养花。
- 搞笑点:夸张的植物生病场景、花友的无厘头行为、搞笑的“拯救”方法。
2. 《花花不听话》
- 剧情简介:主角试图让植物开花,但总是失败。他尝试各种“花友秘籍”,结果植物不仅不开花,还闹出各种笑话,比如把花盆放在阳台却在冬天不开花。
- 搞笑点:植物不听话的反差萌、花友的“花友秘籍”搞笑段子。
3. 《植物界的搞笑大作战》
- 剧情简介:主角是植物爱好者,遇到各种搞笑问题,比如植物长得太慢、叶子发黄、花不开等等。他通过搞笑的方式解决这些问题,比如把花盆放在冰箱里、用咖啡当水等等。
- 搞笑点:夸张的解决方式、植物与人类的反差萌。
4. 《花花大冒险》
- 剧情简介:主角在养花过程中遇到各种搞笑事件,比如植物突然“搬家”、花盆被偷、植物开出奇怪的花等等。他通过幽默的方式解决这些问题,最终成为植物界的“大英雄”。
- 搞笑点:植物的“冒险”、花友的“花友冒险”。
5. 《植物界的超能力者》
- 剧情简介:主角发现植物有“超能力”,比如能自己浇水、能自己施肥、能自己开花。他尝试用这些能力解决问题,但总是闹出笑话,比如把花盆放在阳台却在冬天不开花。
- 搞笑点:植物的“超能力”、花友的“花友冒险”。
如果你喜欢这类搞笑养花短剧,也可以尝试制作自己的“花友搞笑视频”,记录下你养花过程中的趣事,分享给朋友们,让养花变得更有趣!
外卖盒盒养花
外卖盒养花是一种非常有趣且环保的创意方式,但需要注意一些关键点,以确保植物健康生长。耐阴植物:如绿萝、吊兰、常春藤等,适合在光照不足的环境中生长。耐湿植物:如多肉、苔藓植物等,适合在封闭环境中生长。避免高需求植物:如多肉、仙人掌等,可能因浇
· 2025-11-19

养花也疯狂搞笑
养花确实能让人觉得生活有趣,尤其是当它们“疯狂”地生长时。下面是一些搞笑的养花小贴士和趣闻,让你在养花的过程中也能笑出声:浇水是艺术有些植物喜欢“淋浴”,有些则喜欢“滴答滴答”。你可以用喷壶给植物“淋浴”,但别让它们“淋”到叶子上,否则它们
· 2025-11-19

花盆养花客厅造型
花盆的造型在养花过程中起着重要的装饰和功能性作用。根据不同的使用场景和需求,可以选择不同风格和功能的花盆。以下是几种常见的花盆造型及其适用场景:特点:线条简洁,造型现代,适合现代风格的客厅。适用场景:现代简约风格的客厅,搭配绿植和装饰性较强
· 2025-11-19

厌氧菌可以养花嘛
厌氧菌是指在无氧环境下生长的微生物,它们通常在土壤中存在,有助于分解有机物、改善土壤结构。在养花过程中,如果使用了含有厌氧菌的土壤或肥料,可能会对植物生长产生一定影响。答案:可以,但需注意使用方式。促进土壤团粒结构形成:厌氧菌有助于土壤中有
· 2025-11-19
种菜催养花肥
种植蔬菜和花卉时,施肥是保证植物健康生长的重要环节。合理的施肥不仅能促进植物的生长,还能提高产量和品质。以下是关于种菜催养花肥的常见方法和建议:根据植物种类选择肥料 蔬菜类(如番茄、黄瓜、辣椒):需氮磷钾均衡的肥料,促进叶片生长和果实发育
· 2025-11-19

养花土壤沉吗
养花土壤是否沉,主要取决于土壤的密度、透气性和排水性。以下是一些常见的判断方法和改善建议:沉:如果土壤表面看起来松软、潮湿,且不易被手指按压,说明土壤可能过于松散,或者含有过多水分。不沉:如果土壤表面有明显颗粒感,且按压后能回弹,说明土壤结
· 2025-11-19

种植养花花铲
花铲是园艺中常用的工具,主要用于翻土、松土、挖坑、移植等操作。选择合适的花铲可以根据不同的种植需求来决定。1. 花铲的使用方法翻土与松土:花铲可用于翻土,特别是在种植前的土壤准备工作中。使用时,应保持铲子垂直,从下往上铲起,避免伤及植物根系
· 2025-11-19

养花上羊粪吗
在养花过程中,可以适量使用羊粪,但需要注意以下几点:羊粪富含有机质和养分,含有氮、磷、钾等元素,具有一定的肥力。但其pH值通常偏碱性,适合喜碱的植物,如某些花卉和蔬菜。混入土壤:将羊粪与土壤混合,可改善土壤结构,增加肥力。堆肥处理:将羊粪与
· 2025-11-19

养花真好看啊
养花不仅好看,还能美化环境、净化空气、调节心情,对身心健康都有好处。下面是一些养花小贴士,帮助你更好地养护植物:根据你的环境和生活习惯选择适合的植物。例如:室内绿植:适合养在窗边、阳台或客厅的植物,如绿萝、吊兰、仙人掌、多肉等。户外植物:适
· 2025-11-19

养花小白入门指南
养花对于新手来说是一个很好的学习过程,不仅能提升生活品质,还能培养耐心和细心。以下是一些入门指南,帮助你更好地开始养花之旅。1. 选择适合的植物初学者推荐植物:如绿萝、吊兰、仙人掌、多肉、薄荷、芦荟等,这些植物对光照、水分要求较低,适合新手
· 2025-11-19





